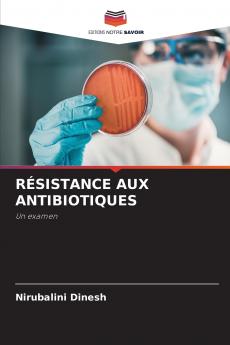
RÉSISTANCE AUX ANTIBIOTIQUES
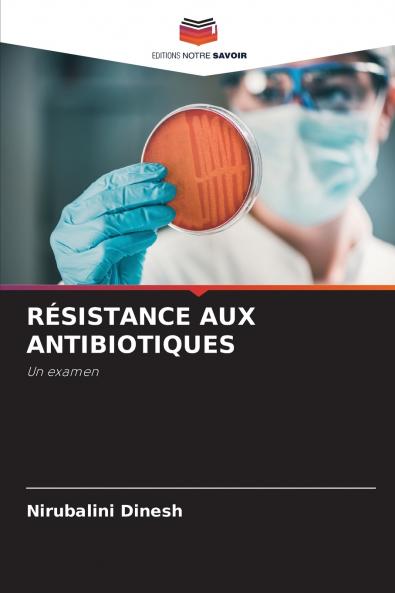
RÉSISTANCE AUX ANTIBIOTIQUES

French
Paperback
₹4773
₹5873
18.73% OFF
(All inclusive*)
Delivery Options
Please enter pincode to check delivery time.
*COD & Shipping Charges may apply on certain items.
Review final details at checkout.
Looking to place a bulk order? SUBMIT DETAILS
Delivery Options
Please enter pincode to check delivery time.
*COD & Shipping Charges may apply on certain items.
Review final details at checkout.
About The Book
Description
Author
La résistance aux antibiotiques des agents responsables des maladies infectieuses est un problème de santé mondial en biologie et en médecine. Les mécanismes de résistance aux antimicrobiens utilisés pour traiter les maladies infectieuses sont connus depuis avant l'introduction des antibiotiques dans l'usage clinique de routine. L'utilisation inconsidérée et souvent excessive des antibiotiques a cependant aggravé le problème en enrichissant les populations bactériennes résistantes au détriment des populations sensibles. L'émergence de la résistance aux antibiotiques entraîne une augmentation de la mortalité de la morbidité et des coûts de traitement. Bien qu'il y ait eu plusieurs indications sur le mauvais usage des antibiotiques par les prestataires de soins de santé les praticiens non qualifiés et les consommateurs de médicaments la sensibilisation et la surveillance du contrôle et de la prévention de la résistance aux antibiotiques dans les secteurs des soins de santé sont encore insuffisantes. Sans action urgente nous nous dirigeons vers une ère post-antibiotique dans laquelle les infections courantes et les blessures mineures peuvent à nouveau tuer. C'est pourquoi ce livre espère faire le point sur la résistance aux antibiotiques à médiation enzymatique et ses mécanismes de développement qui est le mécanisme de résistance le plus largement caractérisé. En outre il recommande des mesures de contrôle.
Details
ISBN 13
9786205383391
Publication Date
-23-11-2022
Pages
-60
Weight
-95 grams
Dimensions
-152x229x3.65 mm